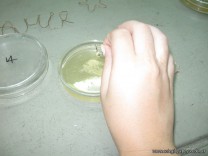

Efecto del Lavado de manos sobre la presencia de Microorganismos
Secundaria – 30 March, 2011
Los alumnos de 6to año, con orientación en Ciencias Naturales en la asignatura Salud, efectuaron cultivos de muestras obtenidas de sus manos, antes del lavado y luego de uno, dos y tres lavados de las mismas. Al cabo de una semana de incubación en estufa, comprobaron el resultado de su experiencia y observaron la presencia de colonias de microorganismos. Luego armaron preparados con las muestras de las colonias y las observaron al microscopio, identificando distintas formas de bacterias y hongos.

Seguí al colegio